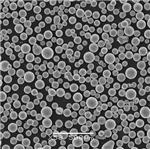
Spherical tungsten powder

Product Details
| Product Name: Spherical tungsten powder | CAS No.: 7440-33-7 |
| EC-No.: 231-143-9 | Min. Order: 1000kg |
| Purity: 99.9% | Supply Ability: 10 tons per month |
| Release date: 2025/03/15 |
Product Description
The porous material prepared from spherical tungsten powder has the characteristic of uniform pore distribution. By controlling the production process, the air permeability of the product can be controlled, and the cathode of high power pulse microwave tube, electron barium tungsten cathode and gas filter material can also be prepared. Due to the good fluidity of spherical tungsten powder, the coating obtained in the field of thermal spraying is more uniform and compact, and the product has good wear resistance.



Specifications
0-20μm, 15-45μm, 15-53μm, 53-105μm, 53-150μm, 105-250μm can be supplied according to customer requirements.
| Trace metallic impurities | |||||
| Element | Value(%wt) | MOA | Element | Value(%wt) | MOA |
| Cr | 0.0006 | ICP-MS | Co | 0.0005 | ICP-MS |
| As | 0.0005 | ICP-MS | Bi | 0.0001 | ICP-MS |
| Si | 0.0005 | ICP-MS | Mo | 0.0016 | ICP-MS |
| Al | 0.0005 | ICP-MS | Ca | 0.0005 | ICP-MS |
| Fe | 0.0010 | ICP-MS | V | 0.0005 | ICP-MS |
| Sb | 0.0005 | ICP-MS | Cd | 0.0001 | ICP-MS |
| Pb | 0.0001 | ICP-MS | Cu | 0.0001 | ICP-MS |
| Mg | 0.0005 | ICP-MS | Ti | 0.0005 | ICP-MS |
| Ni | 0.0005 | ICP-MS | P | 0.0005 | ICP-MS |
| Sn | 0.0001 | ICP-MS | K | 0.0005 | ICP-MS |
| Mn | 0.0005 | ICP-MS | Na | 0.0003 | ICP-MS |
| Nonmetallic impurities | |||||
| Element | Value(%) | MOA | Element | Value(%) | MOA |
| C | 0.0005 | LECO | S | 0.0008 | LECO |
| N | 0.0003 | LECO | O | 0.0100 | LECO |
Package


Applications
Used as the raw material of diamond drill bit and petroleum perforating charge for petroleum drilling,
high temperature coating for combustion chamber and other wear-resistant and high temperature resistant parts.
Company Profile
Yujiang Chemical (Shandong) Co., Ltd. We are located in Shandong with convenient transportation access. We are a professional manufacturer and trader that is concerned with the research, development and production of chemical products. We committed to providing you with high-quality products and services. We always implement the concept of customer value creation, for customers tailored products,
to meet the needs of different customers, and continuously provide customers with solutions and technical problems.Further exploration and innovation, and excellence.Welcome and look forward to customers from all of the world to contact us for create a bright future with us together.






Company Profile Introduction
You may like
Recommended supplier
| Product name | Price | Suppliers | Update time | |
|---|---|---|---|---|
| $/ |
VIP5Y
|
RongNa Biotechnology Co.,Ltd
|
2025-04-29 | |
| $6.00/1kg |
HebeiShuoshengImportandExportco.,Ltd
|
2024-08-02 | ||
| $6.00/1KG |
Hebei Longbang Technology Co., Ltd
|
2024-05-20 | ||
| $6.00/1KG |
Hebei Saisier Technology Co., LTD
|
2024-04-29 | ||
| $0.00/1kg |
Hebei Jingbo New Material Technology Co., Ltd
|
2023-12-08 | ||
| $0.00/1kg |
henan kanbei chemical co.,ltd
|
2022-09-26 | ||
| $51.00/1KG |
Hebei Henghe Import and Export Trading Co. LTD
|
2020-11-23 | ||
| $1.00/1KG |
VIP8Y
|
Career Henan Chemical Co
|
2019-08-30 | |
| $6.00/1KG |
Hebei Saisier Technology Co., LTD
|
2024-03-25 | ||
| $9.00/25kg |
Hebei Jingbo New Material Technology Co., Ltd
|
2023-11-29 |
- Since: 2023-04-24
- Address: Room 010, House 308, No. 350, Juhuashan Road, Huangdao District, Huangdao City, Shandong Province

China
China